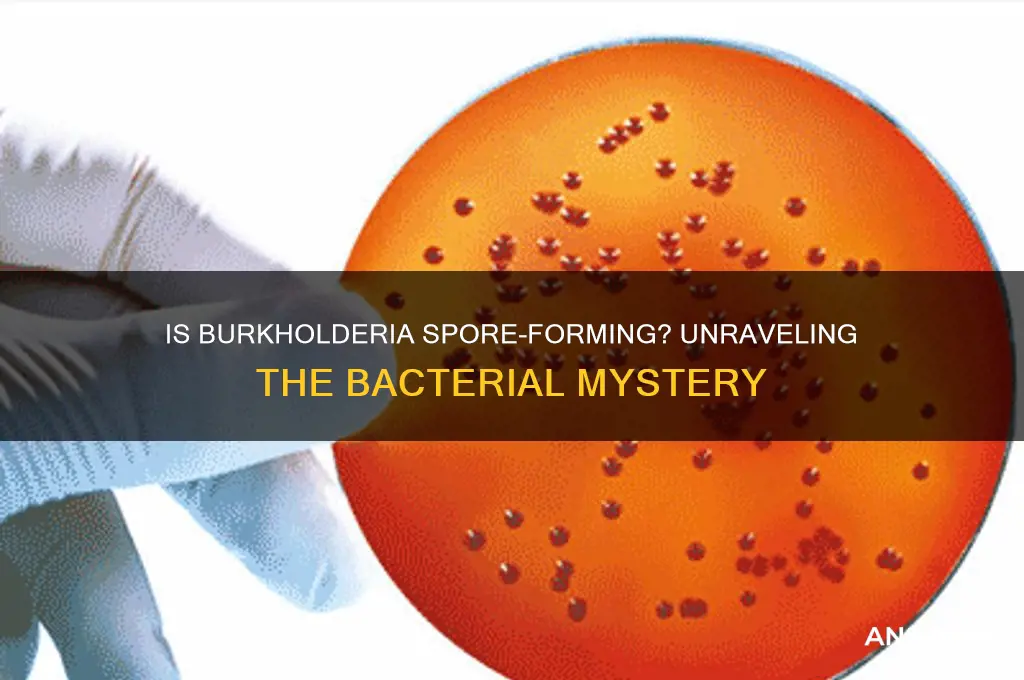
is burkholderia spore forming

Burkholderia is a diverse genus of Gram-negative bacteria known for its environmental adaptability and clinical significance, with species ranging from plant pathogens to opportunistic human pathogens. One common question regarding this genus is whether Burkholderia is spore-forming. Unlike well-known spore-forming bacteria such as Bacillus or Clostridium, Burkholderia species are not known to produce endospores as a survival mechanism. Instead, they rely on other strategies, such as biofilm formation and metabolic versatility, to endure harsh environmental conditions. This distinction is important in understanding their ecology, pathogenicity, and control measures, particularly in clinical and agricultural settings.
What You'll Learn
- Burkholderia spp. classification: Non-spore forming, Gram-negative bacteria, unlike Bacillus or Clostridium
- Reproduction methods: Primarily replicates through binary fission, not sporulation
- Survival strategies: Forms biofilms and persists in diverse environments without spores
- Clinical relevance: Non-spore forming nature impacts disinfection and treatment approaches
- Research findings: Studies confirm Burkholderia lacks spore-forming capabilities across species

Burkholderia spp. classification: Non-spore forming, Gram-negative bacteria, unlike Bacillus or Clostridium
Observation: Burkholderia spp. are classified as non-spore forming, Gram-negative bacteria, setting them apart from spore-forming genera like *Bacillus* and *Clostridium*. This distinction is critical in microbiology, as spore formation is a key survival mechanism for many bacteria, enabling them to withstand harsh conditions such as heat, desiccation, and chemicals. Burkholderia, however, relies on other strategies for persistence, such as biofilm formation and metabolic versatility, which are essential for its environmental and pathogenic roles.
Analytical Insight: Unlike *Bacillus* and *Clostridium*, which produce highly resistant endospores, Burkholderia lacks this ability. This absence of spore formation influences its susceptibility to sterilization methods like autoclaving, where spore-formers require higher temperatures and longer exposure times. For instance, while *Bacillus* spores may survive 121°C for 15 minutes, Burkholderia is effectively eliminated under these conditions due to its non-spore forming nature. This makes Burkholderia easier to control in laboratory and clinical settings but also highlights its reliance on other mechanisms for survival in diverse environments.
Comparative Perspective: The classification of Burkholderia as non-spore forming contrasts sharply with spore-forming bacteria, which are often associated with food spoilage and contamination. For example, *Clostridium botulinum* spores can survive in canned foods, posing a risk of botulism if not properly sterilized. Burkholderia, however, is more commonly found in soil, water, and plant rhizospheres, where its non-spore forming nature limits its ability to persist in processed foods. This difference underscores the importance of understanding bacterial classification in risk assessment and control strategies.
Practical Application: In clinical and industrial settings, knowing that Burkholderia is non-spore forming simplifies disinfection protocols. Standard sterilization methods, such as 70% ethanol or sodium hypochlorite solutions, are effective against Burkholderia, whereas spore-formers may require specialized sporicides like peracetic acid. For healthcare professionals, this distinction is vital when managing infections caused by Burkholderia species, such as *B. cepacia* complex in cystic fibrosis patients, where targeted disinfection can prevent transmission without the need for spore-specific measures.
Takeaway: The non-spore forming nature of Burkholderia spp. is a defining feature that distinguishes it from spore-forming bacteria like *Bacillus* and *Clostridium*. This classification has practical implications for sterilization, infection control, and environmental persistence. By understanding this key difference, microbiologists, clinicians, and industry professionals can implement more effective strategies to manage and mitigate the risks associated with Burkholderia, leveraging its vulnerabilities to non-spore specific disinfection methods.
Mastering Maidenhair Fern Spore Collection: A Step-by-Step Guide
You may want to see also

Reproduction methods: Primarily replicates through binary fission, not sporulation
Burkholderia, a genus of Gram-negative bacteria, primarily replicates through binary fission, a process that divides a single cell into two identical daughter cells. This method is efficient and rapid, allowing Burkholderia to thrive in diverse environments, from soil to clinical settings. Unlike spore-forming bacteria such as Bacillus or Clostridium, Burkholderia lacks the genetic machinery to produce endospores, which are highly resistant structures capable of surviving extreme conditions. This distinction is critical for understanding Burkholderia’s survival strategies and its response to environmental stressors.
Binary fission in Burkholderia follows a precise sequence: DNA replication, cell elongation, and septum formation, culminating in the separation of two genetically identical cells. This asexual reproduction method ensures genetic consistency across generations, which is advantageous for maintaining traits that promote survival in specific niches. However, the absence of sporulation limits Burkholderia’s ability to endure harsh conditions such as desiccation, high temperatures, or prolonged nutrient deprivation. For instance, while Bacillus spores can remain dormant for years, Burkholderia cells rely on active metabolic processes to persist, making them more vulnerable to environmental fluctuations.
From a practical standpoint, understanding Burkholderia’s reliance on binary fission has implications for infection control and treatment. Since it does not form spores, standard disinfection methods targeting vegetative cells—such as alcohol-based sanitizers or heat treatment at 60°C for 30 minutes—are generally effective. However, in healthcare settings, Burkholderia’s ability to form biofilms on surfaces like medical devices complicates eradication efforts. Here, mechanical cleaning followed by chemical disinfection is recommended to disrupt biofilm matrices and eliminate cells.
Comparatively, the lack of sporulation in Burkholderia contrasts with spore-forming pathogens, which require more aggressive measures such as autoclaving at 121°C for 15–30 minutes. This difference underscores the importance of accurate identification in clinical microbiology labs. Misidentifying Burkholderia as a spore-former could lead to unnecessary use of extreme decontamination protocols, while underestimating its biofilm-forming capacity could result in persistent infections. Thus, tailored strategies based on its reproductive and survival mechanisms are essential for effective management.
In conclusion, Burkholderia’s primary reliance on binary fission for reproduction, coupled with its inability to form spores, shapes its ecological and clinical behavior. This knowledge informs targeted disinfection practices, treatment approaches, and risk assessments. While binary fission ensures rapid proliferation under favorable conditions, the absence of sporulation renders Burkholderia more susceptible to environmental controls. Recognizing these nuances is key to mitigating its impact in both natural and healthcare-associated contexts.
Terraforming Planets in Spore: A Step-by-Step Guide to Shaping Worlds
You may want to see also

Survival strategies: Forms biofilms and persists in diverse environments without spores
Burkholderia species are masters of survival, thriving in environments that would challenge most bacteria. Unlike spore-forming bacteria, which rely on dormant, resilient structures to endure harsh conditions, Burkholderia employs alternative strategies to persist. One of its most notable tactics is biofilm formation, a communal lifestyle that enhances its resilience.
Biofilms are structured communities of bacteria encased in a self-produced extracellular matrix, often composed of polysaccharides, proteins, and DNA. For Burkholderia, this matrix acts as a protective shield, safeguarding cells from antibiotics, host immune responses, and environmental stressors like desiccation or pH extremes. For instance, *Burkholderia cepacia* complex (Bcc) species, known for infecting cystic fibrosis patients, form biofilms that resist both host defenses and antimicrobial treatments. To combat this, clinicians often prescribe combination therapies, such as tobramycin (300 mg/dose inhaled twice daily) and ceftazidime (2 g IV every 8 hours), to disrupt biofilm integrity and improve treatment efficacy.
Beyond biofilms, Burkholderia’s metabolic versatility is another key to its survival. These bacteria can utilize a wide range of carbon sources, from simple sugars to complex organic compounds, allowing them to adapt to nutrient-poor environments. For example, *Burkholderia xenovorans* is renowned for its ability to degrade pollutants like polychlorinated biphenyls (PCBs), enabling it to thrive in contaminated soils. This adaptability is further enhanced by its ability to fix nitrogen, a trait rare among pathogenic bacteria, which ensures survival in nitrogen-limited settings.
A comparative analysis highlights the advantages of Burkholderia’s spore-free survival strategies. While spores provide long-term durability, they require specific conditions to form and germinate, limiting their utility in dynamic environments. In contrast, biofilms and metabolic flexibility allow Burkholderia to respond rapidly to changing conditions, ensuring persistence in diverse habitats. For instance, in water distribution systems, *Burkholderia pseudomallei* forms biofilms that resist chlorine disinfection, posing a risk of melioidosis outbreaks. Here, proactive measures like regular pipeline maintenance and biofilm-disrupting agents (e.g., DNase treatments) are essential to mitigate risks.
In practical terms, understanding Burkholderia’s survival mechanisms is crucial for infection control and environmental management. For healthcare settings, surfaces contaminated with Burkholderia biofilms require thorough disinfection using 70% ethanol or hydrogen peroxide-based cleaners. In agricultural contexts, crop rotation and soil remediation can reduce the presence of Burkholderia species that threaten plant health. By targeting biofilms and metabolic pathways, rather than spores, interventions can be tailored to effectively manage these resilient bacteria.
Are Fern Spores Haploid? Unraveling the Mystery of Fern Reproduction
You may want to see also

Clinical relevance: Non-spore forming nature impacts disinfection and treatment approaches
Burkholderia species, unlike spore-forming bacteria such as Bacillus or Clostridium, lack the ability to produce endospores. This non-spore-forming nature significantly influences clinical disinfection and treatment strategies. Without spores, Burkholderia relies on vegetative cells for survival, which are generally more susceptible to disinfectants and environmental stressors. However, this susceptibility does not equate to simplicity in eradication, as Burkholderia’s intrinsic resistance mechanisms, such as efflux pumps and biofilm formation, complicate disinfection efforts in healthcare settings.
Disinfection Approaches: Leveraging Susceptibility
The non-spore-forming characteristic of Burkholderia means standard disinfectants like 70% ethanol, 10% bleach, or quaternary ammonium compounds are effective against vegetative cells. For example, a 10-minute exposure to 10% bleach solution is sufficient to inactivate Burkholderia cepacia complex (BCC) on surfaces, compared to the hours required for spore-forming pathogens like *Clostridioides difficile*. In healthcare facilities, this translates to simpler disinfection protocols for contaminated equipment and environments. However, biofilm formation—a common trait in Burkholderia—can shield cells from disinfectants, necessitating mechanical removal (e.g., scrubbing) before chemical treatment.
Treatment Challenges: Antibiotic Resistance and Biofilms
Clinically, the non-spore-forming nature of Burkholderia simplifies treatment in one aspect: there’s no need for spore-targeting antibiotics like vancomycin or fidaxomicin. However, Burkholderia’s multidrug resistance (MDR) profile, often mediated by efflux pumps and β-lactamases, limits therapeutic options. For cystic fibrosis patients colonized with BCC, combination therapy (e.g., ceftazidime 2 g q8h + trimethoprim/sulfamethoxazole 160/800 mg q12h) is recommended to bypass resistance. Biofilms, which can form on medical devices like catheters or ventilators, further complicate treatment, as cells within biofilms exhibit up to 1000-fold higher antibiotic tolerance. Here, mechanical removal or biofilm-disrupting agents (e.g., DNase) must precede antibiotic therapy.
Practical Tips for Healthcare Providers
For disinfection, verify contact time and concentration of disinfectants, as Burkholderia’s susceptibility is concentration-dependent. In treatment, prioritize combination therapy and monitor for resistance using minimum inhibitory concentration (MIC) testing. For immunocompromised patients, such as those with chronic granulomatous disease, prophylactic measures (e.g., avoiding contaminated water sources) are critical, as Burkholderia can cause life-threatening infections in this population. Lastly, educate patients on biofilm risks, particularly for those with indwelling devices, to prevent recurrent infections.
Comparative Perspective: Spore-Formers vs. Burkholderia
Compared to spore-forming pathogens, Burkholderia’s disinfection and treatment are less resource-intensive but require precision. While spores demand sporicidal agents (e.g., hydrogen peroxide vapor) and prolonged exposure, Burkholderia’s vegetative cells are manageable with routine disinfectants. However, its MDR and biofilm propensity rival the clinical complexity of spore-formers. This duality underscores the need for tailored strategies: exploit its non-spore-forming weakness while addressing its unique resistance mechanisms. By doing so, healthcare providers can effectively mitigate Burkholderia’s clinical impact without over-relying on spore-centric protocols.
Expand Your Spore Tribe Hut: Tips for a Larger Home
You may want to see also

Research findings: Studies confirm Burkholderia lacks spore-forming capabilities across species
Burkholderia, a genus of Gram-negative bacteria, has been extensively studied for its diverse metabolic capabilities and environmental adaptability. However, one question that has persisted in scientific discourse is whether Burkholderia species possess spore-forming capabilities. Recent research findings provide a definitive answer: across all studied species, Burkholderia lacks the ability to form spores. This conclusion is supported by multiple lines of evidence, including genomic analysis, physiological studies, and environmental observations.
Genomic studies have played a pivotal role in confirming Burkholderia's non-spore-forming nature. Unlike spore-forming bacteria such as Bacillus and Clostridium, which possess genes encoding sporulation-specific proteins, Burkholderia genomes lack these critical genetic components. For instance, the absence of genes involved in the formation of the spore coat, cortex, and germ cell wall layers is a consistent finding across Burkholderia species. This genetic evidence strongly suggests that spore formation is not part of Burkholderia's survival strategy, even under harsh environmental conditions.
Physiological experiments further reinforce these genomic findings. Researchers have subjected Burkholderia species to extreme conditions, including desiccation, high temperatures, and nutrient deprivation, which typically trigger spore formation in other bacteria. However, Burkholderia cells consistently fail to undergo morphological changes associated with sporulation. Instead, they rely on alternative survival mechanisms, such as biofilm formation and the production of protective extracellular polymers. These observations highlight the genus's unique approach to environmental stress, distinct from spore-forming bacteria.
Environmental studies provide additional context for Burkholderia's lack of spore-forming capabilities. In natural habitats, Burkholderia species are often found in soil, water, and plant rhizospheres, where they thrive through metabolic versatility and symbiotic relationships. The absence of spores in these environments, even in samples collected from extreme or nutrient-limited sites, supports the laboratory findings. This consistency between lab and field data underscores the reliability of the conclusion that Burkholderia does not form spores.
From a practical standpoint, understanding Burkholderia's non-spore-forming nature has significant implications for infection control and treatment. Unlike spore-forming pathogens, which can persist in dormant states and resist disinfection, Burkholderia infections are more susceptible to standard sterilization methods. For healthcare settings, this means that routine cleaning protocols are generally effective against Burkholderia, reducing the risk of nosocomial outbreaks. However, vigilance is still required, as Burkholderia's environmental resilience and antibiotic resistance pose other challenges.
In summary, research findings unequivocally confirm that Burkholderia lacks spore-forming capabilities across all studied species. This conclusion is supported by genomic, physiological, and environmental evidence, providing a comprehensive understanding of the genus's survival mechanisms. For scientists, clinicians, and environmental specialists, this knowledge is invaluable for developing targeted strategies to manage Burkholderia in various contexts, from healthcare to agriculture.
Mastering Spore Print Storage: Essential Tips for Long-Term Preservation
You may want to see also
Frequently asked questions
No, Burkholderia is not a spore-forming bacterium. It is a Gram-negative, rod-shaped bacterium that does not produce spores as part of its life cycle.
While Burkholderia cannot form spores, some species are highly resilient and can survive in diverse and challenging environments, such as soil, water, and even in association with plants or animals, due to their metabolic versatility.
No, Burkholderia species do not produce spore-like structures. They reproduce primarily through binary fission and do not have the genetic or structural mechanisms to form spores.

